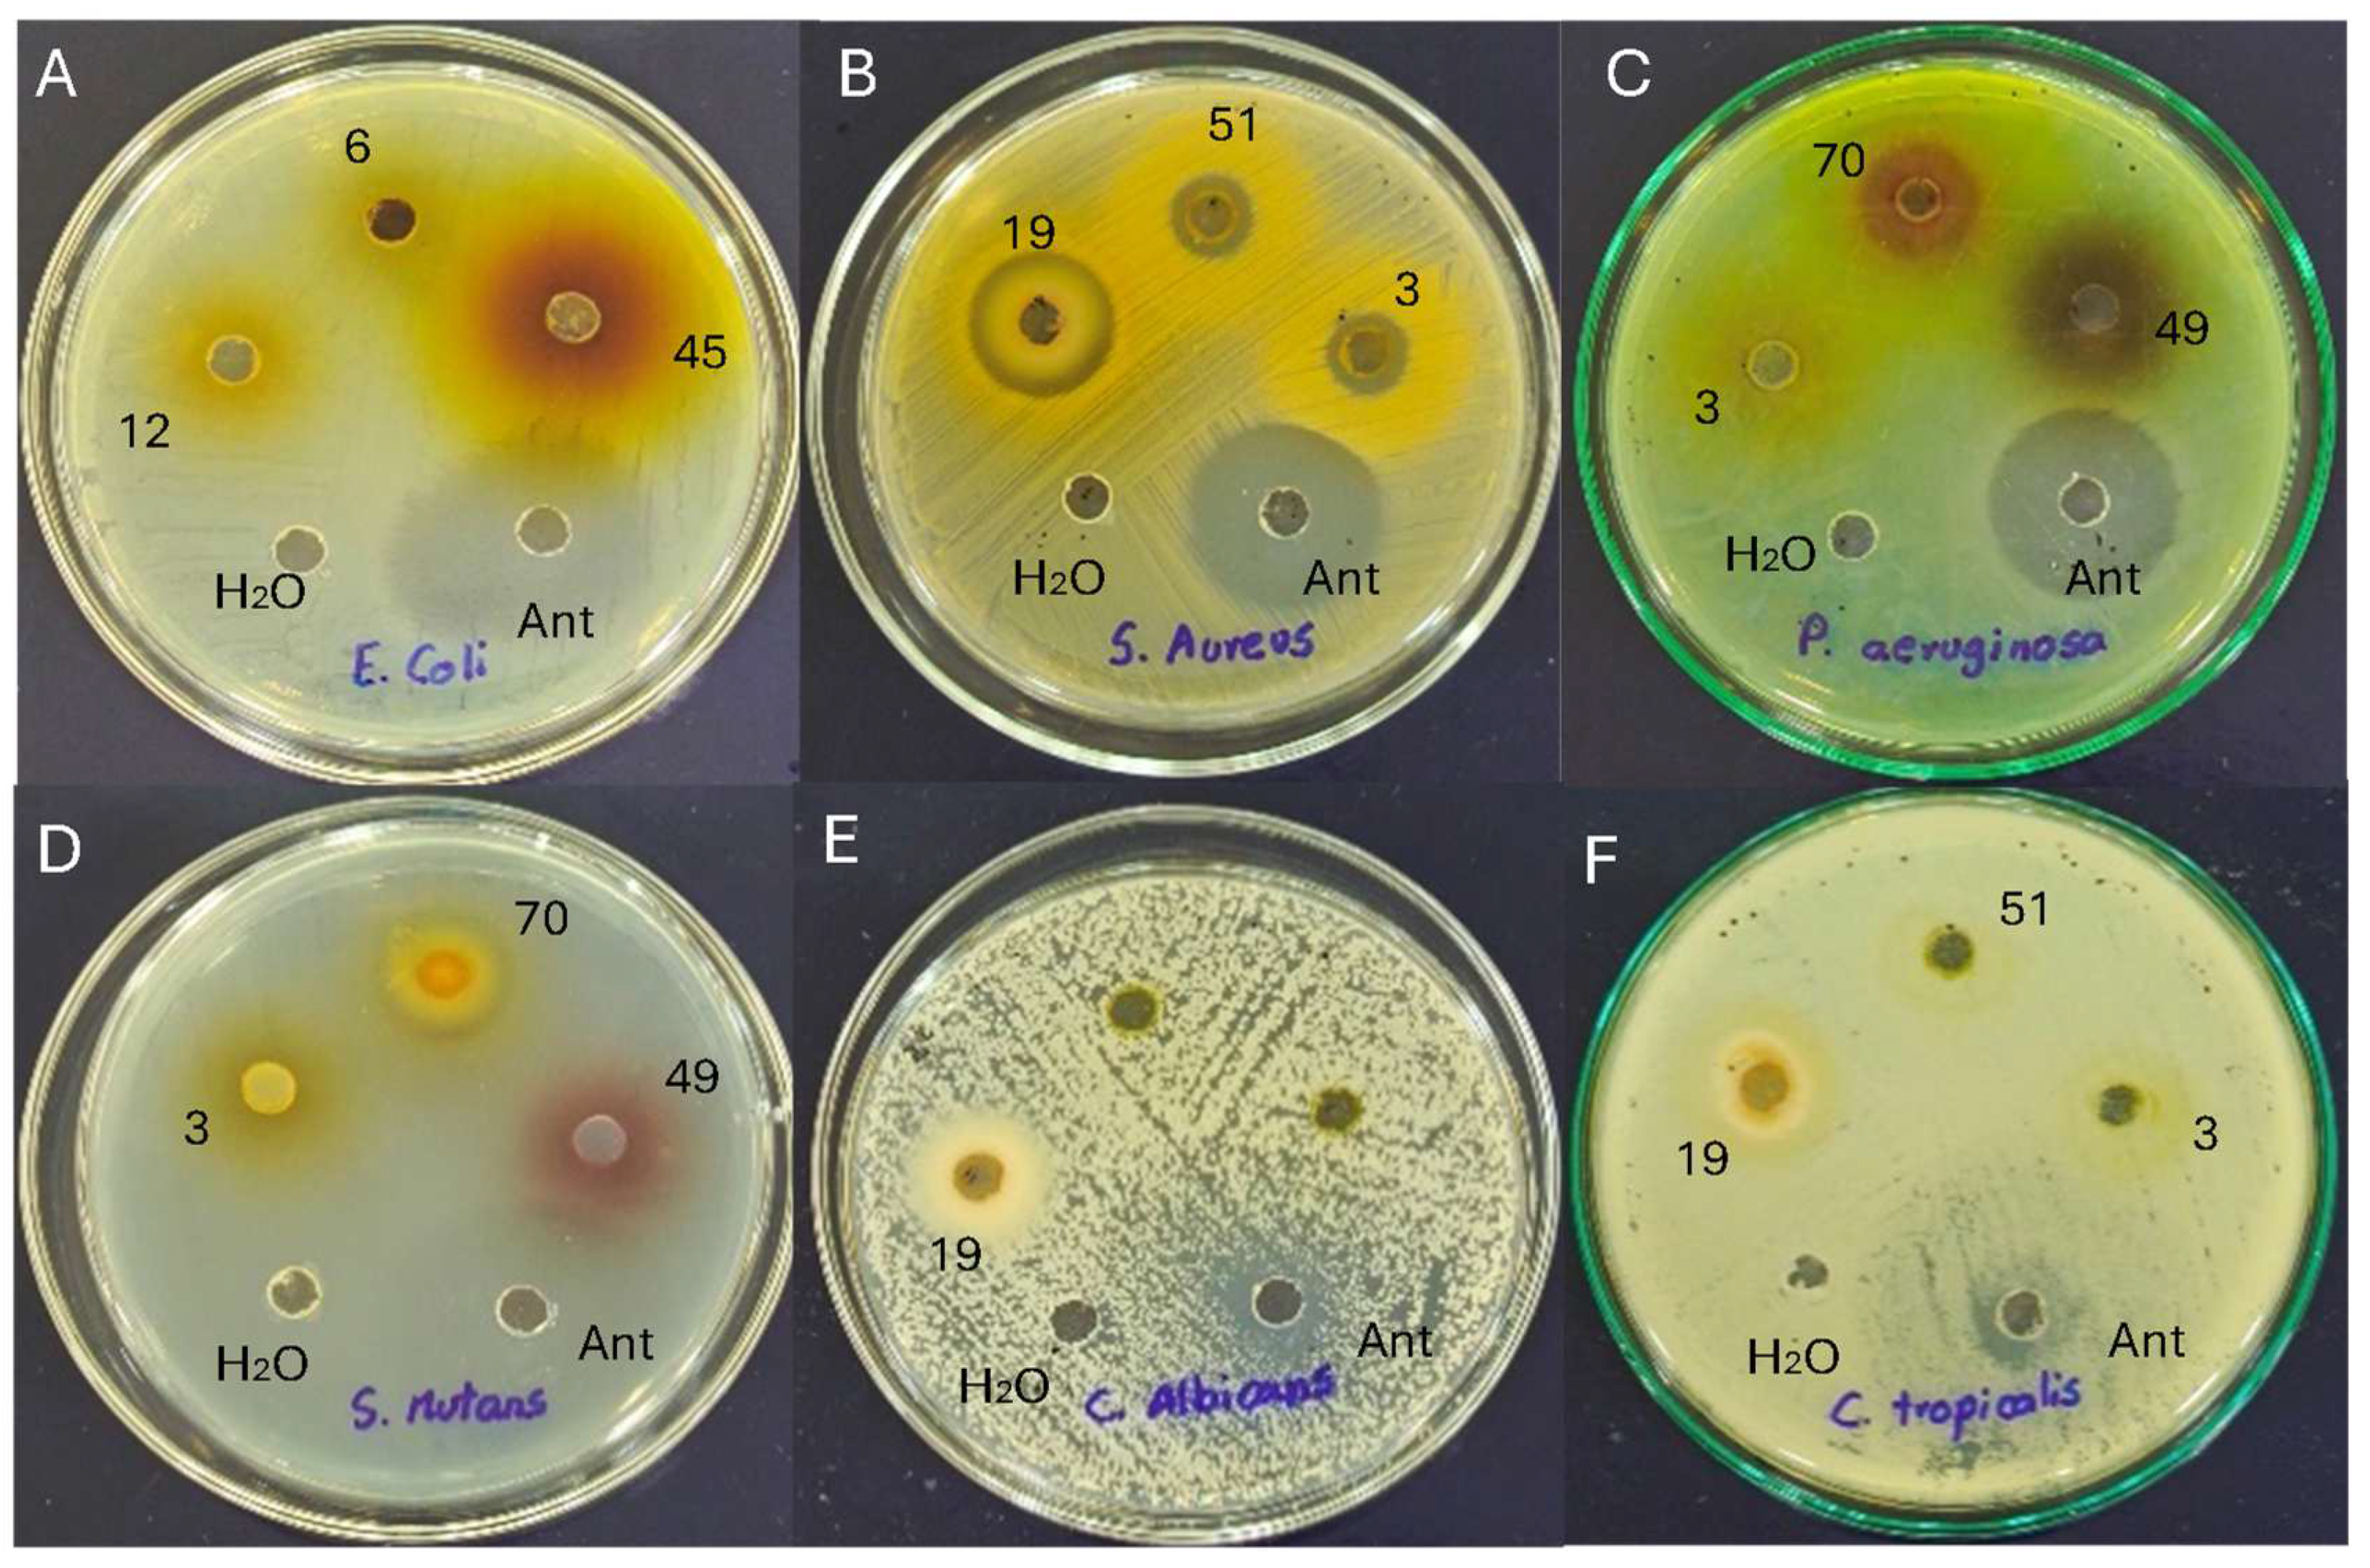

Functional, Antioxidant, Antibacterial, and Antifungal Activity of Edible Flowers
Abstract
1. Introduction
2. Materials and Methods
2.1. Reagents and Standards
2.2. Physicochemical Quantification
2.3. Quantification of Total Carotenoids
2.4. Quantification of Total Phenolic Compounds
2.5. Antioxidant Activity
2.6. Bioactive Compound Profiles
2.6.1. Organic Acid Profile
2.6.2. Phenol Profile
2.6.3. Carotenoid Profile
2.7. Antimicrobial Activity
2.7.1. Preparation of Flower Extracts
2.7.2. Preparation of Inoculum
2.7.3. Well Diffusion Assay
2.8. Statistical Analysis
3. Results
3.1. Physicochemical Quantification
3.2. Quantification of Total Carotenoids and Phenols and Antioxidants Activity
3.3. Bioactive Compound Profiles
3.4. Antimicrobial Activity
4. Discussion
4.1. Physicochemical Quantification
4.2. Quantification of Total Carotenoids and Phenols and Antioxidants Activity
4.3. General Statistical Analysis
4.4. Bioactive Compound Profiles
4.5. Antimicrobial Activity
4.6. Specific Statistical Analysis
5. Conclusions
Supplementary Materials
Author Contributions
Funding
Institutional Review Board Statement
Informed Consent Statement
Data Availability Statement
Conflicts of Interest
References
- Gokiladevi, R.; Varsini, K.; Shafrin, K.; Nithya, R. Edible Flowers: Blooming Delicacies for Health and Wealth. Futur Trends Agric. Eng. Food Sci. 2024, 3, 77–88. [Google Scholar]
- Fernandes, L.; Casal, S.; Pereira, J.; Saraiva, J.; Ramalhosa, E. An Overview on the Market of Edible Flowers. Food Rev. Int. 2020, 36, 258–275. [Google Scholar] [CrossRef]
- Dos-Santos, I.; Reis, S. Edible Flowers: Traditional and Current Use. Ornam. Hortic. 2021, 27, 438–445. [Google Scholar] [CrossRef]
- Madurangi, A.; Maduwanthi, S. Edible Flowers in Herbal Beverage Development. Asian Food Sci. J. 2024, 23, 1–21. [Google Scholar] [CrossRef]
- Sood, Y.; Lal, M.; Kalia, A.; Verma, S. Edible Flowers: Super Foods with Potential Health Benefits. Int. J. Plant Soil Sci. 2024, 36, 213–221. [Google Scholar] [CrossRef]
- Coyago-Cruz, E.; Moya, M.; Méndez, G.; Villacís, M.; Rojas-Silva, P.; Corell, M.; Mapelli-Brahm, P.; Vicario, I.; Meléndez-Martínez, A. Exploring Plants with Flowers: From Therapeutic Nutritional Benefits to Innovative Sustainable Uses. Foods 2023, 12, 4066. [Google Scholar] [CrossRef]
- Dastidar, A.; Chakraborty, S.; Saha, A.; Das, S.; Zaman, Q. Edible Flowers: A New Source of Minerals. Int. J. Res. Appl. Sci. Eng. Technol. 2023, 11, 38–54. [Google Scholar] [CrossRef]
- Bagade, R.; Salunkhe, S.; Edake, K.; Shendage, B.; Tarade, P. Antimicrobial Activity of Medicinal Plants. Int. J. Res. Appl. Sci. Eng. Technol. 2024, 12, 565–567. [Google Scholar] [CrossRef]
- Primitivo, M.; Neves, M.; Pires, C.; Cruz, P.; Brito, C.; Rodrigues, A.; de Carvalho, C.; Mortimer, M.; Moreno, M.; Brito, R.; et al. Edible Flowers of Helichrysum italicum: Composition, Nutritive Value, and Bioactivities. Food Res. Int. 2022, 157, 111399. [Google Scholar] [CrossRef]
- Liu, A.; Wan, Q.; Li, J.; Li, Q.; Hu, K.; Ao, X.; Chen, S.; He, L.; Hu, X.; Hu, B.; et al. Rose Bud Extract as a Natural Antimicrobial Agent against Staphylococcus aureus: Mechanisms and Application in Maintaining Pork Safety. LWT 2023, 176, 114527. [Google Scholar] [CrossRef]
- Pereira, A.; Silva, A.; Grosso, C.; Echave, J.; Chamorro, F.; Seyyedi-Mansour, S.; Donn, P.; Fraga-Corral, M.; Barroso, M.F.; Prieto, M. Antimicrobial Activity Screening of Camellia japonica Flowers (Var. Carolyn Tuttle) for Potential Drug Development. Eng. Proc. 2023, 56, 314. [Google Scholar] [CrossRef]
- Meléndez-Martínez, A.; Benítez, A.; Corell, M.; Hernanz, D.; Mapelli-Brahm, P.; Stinco, C.; Coyago-Cruz, E. Screening for Innovative Sources of Carotenoids and Phenolic Antioxidants among Flowers. Foods 2021, 10, 2625. [Google Scholar] [CrossRef] [PubMed]
- Coyago-Cruz, E.; Guachamin, A.; Méndez, G.; Moya, M.; Viera, W.; Heredia-Moya, J.; Beltrán, E.; Vera, E.; Villacís, M. Functional and Antioxidant Evaluation of Two Ecotypes of Control and Grafted Tree Tomato (Solanum betaceum) at Different Altitudes. Foods 2023, 12, 3494. [Google Scholar] [CrossRef] [PubMed]
- ISO-1842; East African Standard. Fruits, Vegetables and Derived Products-Sampling and Methods of Test; EAS-41-5:2000. ISO: Geneva, Switzerland, 2000.
- US-ISO-2173:2003; Fruit and Vegetable Products. Determination of Soluble Solids. Refractometric Method. ISO: Geneva, Switzerland, 2009.
- US-ISO-750:1998; Fruit and Vegetable Products—Determination of Titratable Acidity. ISO: Geneva, Switzerland, 2009.
- Coyago-Cruz, E.; Guachamin, A.; Vera, E.; Moya, M.; Heredia-Moya, J.; Beltrán, E. Physicochemical Characteristics and Antioxidant Capacity of Ecuadorian Paramo Flowers. Rev. Bionat. 2023, 8, 21. [Google Scholar] [CrossRef]
- Coyago-Cruz, E.; Corell, M.; Meléndez-Martínez, A. Estudio Sobre El Contenido En Carotenoides y Compuestos Fenólicos de Tomates y Flores En El Contexto de La Alimentación Funcional; Punto Rojo Libros, S.L.: Sevilla, España, 2017; ISBN 9788417148096. [Google Scholar]
- Periago, M.J.; Martínez-Valverde, I.; Chesson, A.; Provan, G. Phenolic Compounds, Lycopene and Antioxidant Activity in Commercial Varieties of Tomato (Lycopersicum esculentum). J. Sci. Food Agric. 2002, 82, 323–330. [Google Scholar] [CrossRef]
- Bobo-García, G.; Davidov-Pardo, G.; Arroqui, C.; Vírseda, P.; Marín-Arroyo, M.R.; Navarro, M. Intra-Laboratory Validation of Microplate Methods for Total Phenolic Content and Antioxidant Activity on Polyphenolic Extracts, and Comparison with Conventional Spectrophotometric Methods. J. Sci. Food Agric. 2015, 95, 204–209. [Google Scholar] [CrossRef]
- Stinco, C.; Benítez-González, A.; Meléndez-Martínez, A.; Hernanz, D.; Vicario, I. Simultaneous Determination of Dietary Isoprenoids (Carotenoids, Chlorophylls and Tocopherols) in Human Faeces by Rapid Resolution Liquid Chromatography. J. Chromatogr. A 2019, 1583, 63–72. [Google Scholar] [CrossRef]
- CLSI M02; Performance Standards for Antimicrobial Disk Suspectibility Tests, Approved Standard-Eleventh Edition. Clinical and Laboratory Standards Institue: Wayne, PA, USA, 2018.
- CLSI M44-A2; Method for Antifungal Disk Diffusion Susceptibility Testing of Yeasts. Approved Guideline—Second Edition. Clinical and Laboratory Standards Institue: Wayne, PA, USA, 2009.
- Balouiri, M.; Sadiki, M.; Ibnsouda, S. Methods for in Vitro Evaluating Antimicrobial Activity: A Review. J. Pharm. Anal. 2016, 6, 71–79. [Google Scholar] [CrossRef]
- Cho, L.; Yoon, J.; An, G. The Control of Flowering Time by Environmental Factors. Plant J. 2017, 90, 708–719. [Google Scholar] [CrossRef]
- Zonneveld, B. The DNA Weights per Nucleus (Genome Size) of More than 2350 Species of the Flora of The Netherlands, of Which 1370 Are New to Science, Including the Pattern of Their DNA Peaks. Forum Geobot. 2019, 8, 24–78. [Google Scholar] [CrossRef]
- Bennurmath, P. Assessment of Qualitative and Quantitative Parameters of Different Chrysanthemum Genotypes. Indian J. Pure Appl. Biosci. 2020, 8, 235–240. [Google Scholar] [CrossRef]
- Khristi, V.; Patel, V.H. Therapeutic Potential of Hibiscus rosa sinensis: A Review. Int. J. Nutr. Diet. 2017, 4, 105–123. [Google Scholar] [CrossRef]
- Abdullah; Mehmood, F.; Shahzadi, I.; Waseem, S.; Mirza, B.; Ahmed, I.; Waheed, M.T. Chloroplast Genome of Hibiscus rosa-sinensis (Malvaceae): Comparative Analyses and Identification of Mutational Hotspots. Genomics 2020, 112, 581–591. [Google Scholar] [CrossRef]
- Slamet, A. The Diversity of Hibiscus rosa-sinensis Based on Morphological Approach. Sci. Educ. 2018, 7, 33–41. [Google Scholar] [CrossRef]
- Ramírez-Cortés, B.; Caro-Velarde, F.; Valdivia-Reynoso, M.; Ramírez-Lozano, M.; Machuca-Sánchez, L. Cambios En Tamaño y Características Químicas de Cálices de Jamaica (Hibiscus sabdariffa L.) Durante Su Maduración. Rev. Chapingo Ser. Hortic. 2011, XVII, 19–31. [Google Scholar] [CrossRef]
- Gomes, R.; Andrade, C.; Aguiar, T.; Cavestré, R.; Guimaraes, M.; Cardoso, W. Postharvest of Edible Flowers. Pesqui. Agropecu. Bras. 2022, 57, e02953. [Google Scholar] [CrossRef]
- Li, C.; He, M.; Cai, Z.; Qi, H.; Zhang, J.; Zhang, C. Hyperspectral Imaging with Machine Learning Approaches for Assessing Soluble Solids Content of Tribute Citru. Foods 2023, 12, 247. [Google Scholar] [CrossRef]
- Magri, A.; Adiletta, G.; Petriccione, M. Evaluation of Antioxidant Systems and Ascorbate-Glutathione Cycle in Feijoa Edible Flowers at Different Flowering Stages. Foods 2020, 9, 95. [Google Scholar] [CrossRef]
- Domene, M.; Segura, M. Parámetros de Calidad Interna de Hortalizas y Frutas En La Industria Agroalimentaria. 2014. Available online: https://www.cajamar.es/storage/documents/005-calidad-interna-1410512030-cc718.pdf (accessed on 22 September 2024).
- Rivera, E.; Cruz, O.; Mejía, J.; García, M.; Colina, M.; Martínez, M. Physicochemical Quality, Antioxidant Capacity and Nutritional Value of Edible Flowers of Some Wild Dahlia Species. Folia Hortic. 2019, 31, 331–342. [Google Scholar] [CrossRef]
- Marchioni, I.; Najar, B.; Ruffoni, B.; Copetta, A.; Pistelli, L.; Pistelli, L. Bioactive Compounds and Aroma Profile of Some Lamiaceae Edible Flowers. Plants 2020, 9, 691. [Google Scholar] [CrossRef]
- De-Lima, F.; Rodrigues, M.; Lidório, H.; Menegaes, J.; Martins, L. Chemical Composition of Rose, Sunflower and Calendula Flower Petals for Human Food Use. Cienc. Tecnol. Agropecu. 2019, 20, 159–168. [Google Scholar]
- Harrap, M.; Hempel, N.; Knowles, H.; Whitney, H.; Rands, S. Floral Humidity in Flowering Plants: A Preliminary Survey. Front. Plant Sci. 2020, 11, 249. [Google Scholar] [CrossRef] [PubMed]
- Afify, A.; Hassan, H. Free Radical Scavenging Activity of Three Different Flowers-Hibiscus rosa-sinensis, Quisqualis Indica and Senna Surattensis. Asian Pac. J. Trop. Biomed. 2016, 6, 771–777. [Google Scholar] [CrossRef]
- Khan, Z.A.; Naqvi, S.A.R.; Mukhtar, A.; Hussain, Z.; Shahzad, S.A.; Mansha, A.; Ahmad, M.; Zahoor, A.F.; Bukhari, I.H.; Ashraf Janjua, M.R.S.; et al. Antioxidant and Antibacterial Activities of Hibiscus rosa-sinensis Linn Flower Extracts. Pak. J. Pharm. Sci. 2014, 27, 469–474. [Google Scholar]
- Soni, K.; Loonker, S. An Approach to Leading Antioxidant Activity of Different Plants and Food Material: A Review. Orient. J. Chem. 2022, 38, 663–670. [Google Scholar] [CrossRef]
- Lang, Y.; Gao, N.; Zang, Z.; Meng, X.; Lin, Y.; Yang, S.; Yang, Y.; Jin, Z.; Li, B. Classification and Antioxidant Assays of Polyphenols: A Review. J. Futur. Foods 2024, 4, 193–204. [Google Scholar] [CrossRef]
- Kaczmarek-Szczepańska, B.; Grabska-Zielińska, S.; Michalska-Sionkowska, M. The Application of Phenolic Acids in the Obtainment of Packaging Materials Based on Polymers—A Review. Foods 2023, 12, 1343. [Google Scholar] [CrossRef]
- Klran, T.R.; Otlu, O.; Karabulut, A.B. Oxidative Stress and Antioxidants in Health and Disease. J. Lab. Med. 2023, 47, 1–11. [Google Scholar] [CrossRef]
- Meléndez-Martínez, A.J. Carotenoides En Agroalimentación y Salud; Editorial Terracota: Ciudad de México, Mexico, 2017; ISBN 9788415413356. [Google Scholar]
- Muzolf-Panek, M.; Waśkiewicz, A. Relationship between Phenolic Compounds, Antioxidant Activity and Color Parameters of Red Table Grape Skins Using Linear Ordering Analysis. Appl. Sci. 2022, 12, 6146. [Google Scholar] [CrossRef]
- Pandurangaiah, S.; Sadashiva, A.T.; Shivashankar, K.S.; Sudhakar Rao, D.V.; Ravishankar, K.V. Carotenoid Content in Cherry Tomatoes Correlated to the Color Space Values L*, A*, B*: A Non-Destructive Method of Estimation. J. Hortic. Sci. 2020, 15, 27–34. [Google Scholar] [CrossRef]
- Coyago-Cruz, E.; Corell, M.; Moriana, A.; Hernanz, D.; Stinco, C.; Meléndez-Martínez, A. Effect of the Fruit Position on the Cluster on Fruit Quality, Carotenoids, Phenolics and Sugars in Cherry Tomatoes (Solanum lycopersicum L.). Food Res. Int. 2017, 100, 804–813. [Google Scholar] [CrossRef] [PubMed]
- Mengfei, H.; Shuihong, C.; Dong, W. Effects of Organic Acids Content in Roots and Root Exudates of Hordeum bogdanii by Endophytic Fungi. Res. Sq. 2023, 12, 1–12. [Google Scholar]
- Moreira, J.; Souza, L.; Picanco, W.; Moraes, M.; Degaut, F.; Ramos, F.; Ferreira, V.; Henrique, P.; Aparecido, E.; De-Araújo, J. Edible Flowers from Theobroma speciosum: Aqueous Extract Rich in Antioxidant Compounds. Food Chem. 2021, 356, 129723. [Google Scholar] [CrossRef]
- Shi, Y.; Pu, D.; Zhou, X.; Zhang, Y. Recent Progress in the Study of Taste Characteristics and the Nutrition and Health Properties of Organic Acids in Foods. Foods 2022, 11, 3408. [Google Scholar] [CrossRef]
- Khare, T.; Anand, U.; Dey, A.; Assaraf, Y.; Chen, Z.; Liu, Z.; Kumar, V. Exploring Phytochemicals for Combating Antibiotic Resistance in Microbial Pathogens. Front. Pharmacol. 2021, 12, 720726. [Google Scholar] [CrossRef]
- Al-Harbi, S.; Al-Judaibi, A. Relationship between Escherichia coli and Colon Cancer. GSC Biol. Pharm. Sci. 2020, 12, 188–193. [Google Scholar] [CrossRef]
- Liu, L.; Ma, X.; Bilal, M.; Wei, L.; Tang, S.; Luo, H.; Zhao, Y.; Wang, Z.; Duan, X. Toxicity and Inhibition Mechanism of Gallic Acid on Physiology and Fermentation Performance of Escherichia coli. Bioresour. Bioprocess. 2022, 9, 76. [Google Scholar] [CrossRef] [PubMed]
- Wang, L.; Zhang, Y.; Liu, Y.; Xu, M.; Yao, Z.; Zhang, X.; Sun, Y.; Zhou, T.; Shen, M. Effects of Chlorogenic Acid on Antimicrobial, Antivirulence, and Anti-Quorum Sensing of Carbapenem-Resistant Klebsiella pneumoniae. Front. Microbiol. 2022, 13, 997310. [Google Scholar] [CrossRef]
- Kang, J.-W.; Lee, H.-Y.; Kang, D.-H. Synergistic Bactericidal Effect of Hot Water with Citric Acid against Escherichia coli O157:H7 Biofilm Formed on Stainless Steel. Food Microbiol. 2021, 95, 103676. [Google Scholar] [CrossRef]
- Hodaei, M.; Rahimmalek, M.; Arzani, A. Variation in Bioactive Compounds, Antioxidant and Antibacterial Activity of Iranian Chrysanthemum morifolium Cultivars and Determination of Major Polyphenolic Compounds Based on HPLC Analysis. J. Food Sci. Technol. 2021, 58, 1538–1548. [Google Scholar] [CrossRef]
- Khameneh, B.; Eskin, N.; Iranshahy, M.; Fazly, B. Phytochemicals: A Promising Weapon in the Arsenal against Antibiotic-resistant Bacteria. Antibiotics 2021, 10, 1044. [Google Scholar] [CrossRef] [PubMed]
- Bai, H.; Zhao, F.; Li, M.; Qin, L.; Yu, H.; Lu, L.; Zhang, T. Citric Acid Can Force Staphylococcus aureus into Viable but Nonculturable State and Its Characteristics. Int. J. Food Microbiol. 2019, 305, 108254. [Google Scholar] [CrossRef]
- Mahavy, C.; Mol, A.; Andrianarisoa, B.; Duez, P.; Jaziri, M.; Baucher, M.; Rasamiravaka, T. The Xanthophyll Carotenoid Lutein Reduces the Invasive Potential of Pseudomonas aeruginosa and Increases Its Susceptibility to Tobramycin. Int. J. Mol. Sci. 2022, 23, 7199. [Google Scholar] [CrossRef] [PubMed]
- Hassan, A.; Egbe, N.; Appah, J.; Garba, S. Plants Phenolics as Possible Pseudomonas aeruginosa Resistance Inhibitors. Asian Plant Res. J. 2023, 11, 1–9. [Google Scholar] [CrossRef]
- Dame-Teixeira, N.; El-Gendy, R.; Monici, I.; Holanda, C.; De-Oliveira, A.; Romeiro, L.; Do, T. Sustainable Multifunctional Phenolic Lipids as Potential Therapeutics in Dentistry. Sci. Rep. 2022, 12, 9299. [Google Scholar] [CrossRef]
- Possamai, F.; Tharmalingam, N.; Escobar, I.; D’azevedo, P.; Rigon, K.; Mylonakis, E. Antifungal Activity of the Phenolic Compounds Ellagic Acid (Ea) and Caffeic Acid Phenethyl Ester (Cape) against Drug-Resistant Candida auris. J. Fungi 2021, 7, 763. [Google Scholar] [CrossRef] [PubMed]
- Salas-Pérez, L.; Monserrat, J.; Delgado, G.; Preciado-Rangel, P.; Antonio, J.; Fuentes, G.; Velia, A.; Garay, A.; Ángel, M.; Castruita, S. The Application of Citric Acid Increases the Quality and Antioxidant Capacity of Lentil Sprouts. Rev. Mex. Ciencias Agrícolas Spec. 2018, 9, 4301–4309. [Google Scholar]
- Christofi, T.; Panayidou, S.; Dieronitou, I.; Michael, C.; Apidianakis, Y. Metabolic Output Defines Escherichia coli as a Health-Promoting Microbe against Intestinal Pseudomonas aeruginosa. Sci. Rep. 2019, 9, 14463. [Google Scholar] [CrossRef]
- Bandara, H.; Yau, J.; Watt, R.; Jin, L.; Samaranayake, L. Escherichia coli and Its Lipopolysaccharide Modulate In Vitro Candida Biofilm Formation. J. Med. Microbiol. 2009, 58, 1623–1631. [Google Scholar] [CrossRef]
- Liu, Y.; Gloag, E.S.; Hill, P.J.; Parsek, M.R.; Wozniak, D.J. Interbacterial Antagonism Mediated by a Released Polysaccharide. J. Bacteriol. 2022, 204, e00076-22. [Google Scholar] [CrossRef]
- Coulter, A.; Greenway, F.; Zhang, D.; Ghosh, S.; Coulter, C.; James, S.; He, Y.; Cusimano, L.; Rebello, C. Naringenin and β-Carotene Convert Human White Adipocytes to a Beige Phenotype and Elevate Hormone-Stimulated Lipolysis. Front. Endocrinol. 2023, 14, 1–16. [Google Scholar] [CrossRef] [PubMed]
- Coyago-Cruz, E.; Corell, M.; Stinco, C.; Hernanz, D.; Moriana, A.; Meléndez-Martínez, A. Effect of Regulated Deficit Irrigation on Quality Parameters, Carotenoids and Phenolics of Diverse Tomato Varieties (Solanum lycopersicum L.). Food Res. Int. 2017, 96, 72–83. [Google Scholar] [CrossRef] [PubMed]

| N° | Family | Species | Sampling Location | Altitude (masl) | |
|---|---|---|---|---|---|
| 1 | Apiaceae | Anethum graveolens (yellow) | 1.0°18.0′52.0″ S | 78.0°31.0′46.0″ W | 2350 |
| 2 | Asteraceae | Chrysanthemum x hybrid (pink) | 2.0°53.0′11.0″ S | 78.0°59.0′23.0″ W | 2728 |
| 3 | Chrysanthemum x hybrid (orange) | 2.0°53.0′11.0″ S | 78.0°59.0′23.0″ W | 2728 | |
| 4 | Chrysanthemum x hybrid (yellow) | 2.0°53.0′11.0″ S | 78.0°59.0′23.0″ W | 2728 | |
| 5 | Chrysanthemum x hybrid (yellow-double) | 1.0°23.0′43.0″ S | 78.0°26.0′18.0″ W | 1600 | |
| 6 | Helianthus annuus (yellow) | 0.0°10.0′58.7″ S | 78.0°22.0′59.9″ W | 2339 | |
| 7 | Tagetes patula (orange) | 0.0°9.0′0.0″ S | 78.0°25.0′60.0″ W | 2600 | |
| 8 | Tagetes patula (yellow) | 0.0°09.0′0.0″ S | 78.0°25.0′60.0″ W | 2600 | |
| 9 | Begoniaceae | Begonia doblet (pink) | 0.0°10.0′58.7″ S | 78.0°22.0′59.5″ W | 2339 |
| 10 | Brasicaceae | Raphanus raphanistrum (pink) | 0.0°09.0′0.0″ S | 78.0°25.0′60.0″ W | 2600 |
| 11 | Cannaceae | Canna indica (red-double) | 0.0°11.0′19.0″ S | 78.0°23.0′46.0″ W | 2360 |
| 12 | Canna indica (red) | 0.0°05.0′14.0″ S | 78.0°26.0′59.9″ W | 2610 | |
| 13 | Canna indica (yellow-orange) | 0.0°11.0′19.0″ S | 78.0°23.0′46.0″ W | 2360 | |
| 14 | Caryophyllaceae | Dianthus chinensis (pink) | 0.0°09.0′0.0″ S | 78.0°25.0′60.0″ W | 2600 |
| 15 | Dianthus chinensis (red) | 0.0°09.0′0.0″ S | 78.0°25.0′60.0″ W | 2600 | |
| 16 | Pelargonium hortorum (fuchsia1) | 0.0°09.0′0.0″ S | 78.0°25.0′60.0″ W | 2600 | |
| 17 | Pelargonium hortorum (fuchsia2) | 0.0°20.0′4.8″ S | 78.0°33.0′57.7″ W | 3121 | |
| 18 | Pelargonium hortorum (orange1) | 0.0°09.0′0.0″ S | 78.0°25.0′60.0″ W | 2600 | |
| 19 | Pelargonium hortorum (orange2) | 0.0°20.0′4.8″ S | 78.0°33.0′57.7″ W | 3121 | |
| 20 | Pelargonium hortorum (pink1) | 0.0°09.0′0.0″ S | 78.0°25.0′60.0″ W | 2600 | |
| 21 | Pelargonium hortorum (pink2) | 0.0°09.0′0.0″ S | 78.0°25.0′60.0″ W | 2600 | |
| 22 | Pelargonium hortorum (pink3) | 0.0°09.0′0.0″ S | 78.0°25.0′60.0″ W | 2600 | |
| 23 | Pelargonium hortorum (pink4) | 0.0°20.0′4.8″ S | 78.0°33.0′57.7″ W | 3121 | |
| 24 | Pelargonium hortorum (pink-fuchsia) | 0.0°09.0′0.0″ S | 78.0°25.0′60.0″ W | 2600 | |
| 25 | Pelargonium hortorum (pink-white1) | 0.0°09.0′0.0″ S | 78.0°25.0′60.0″ W | 2600 | |
| 26 | Pelargonium hortorum (pink-white2) | 0.0°09.0′0.0″ S | 78.0°25.0′60.0″ W | 2600 | |
| 27 | Pelargonium hortorum (red1) | 0.0°09.0′0.0″ S | 78.0°25.0′60.0″ W | 2600 | |
| 28 | Pelargonium hortorum (red2) | 0.0°09.0′0.0″ S | 78.0°25.0′60.0″ W | 2600 | |
| 29 | Pelargonium hortorum (white1) | 0.0°09.0′0.0″ S | 78.0°25.0′60.0″ W | 2600 | |
| 30 | Pelargonium hortorum (white2) | 0.0°20.0′4.8″ S | 78.0°33.0′57.7″ W | 3121 | |
| 31 | Compositae | Calendula officinalis(yellow) | 1.0°23.0′43.0″ S | 78.0°26.0′18.0″ W | 1600 |
| 32 | Chamaemelun nobile (white) | 1.0°11.0′51.5″ S | 78.0°32.0′9.1″ W | 2908 | |
| 33 | Dahlia pinnata (fuchsia1) | 1.0°19.0′19.0″ S | 78.0°30.0′46.0″ W | 2360 | |
| 34 | Dahlia pinnata (fuchsia2) | 1.0°23.0′43.0″ S | 78.0°26.0′18.0″ W | 1600 | |
| 35 | Dahlia pinnata (orange) | 1.0°23.0′43.0″ S | 78.0°26.0′18.0″ W | 1600 | |
| 36 | Dahlia pinnata (red) | 1.0°23.0′43.0″ S | 78.0°26.0′18.0″ W | 1600 | |
| 37 | Fabaceae | Trifolium repens (white) | 1.0°23.0′43.0″ S | 78.0°26.0′18.0″ W | 1600 |
| 38 | Geraniaceae | Pelargonium hortorum (fuchsia1) | 0.0°10.0′58.7″ S | 78.0°22.0′59.5″ W | 2339 |
| 39 | Pelargonium hortorum (fuchsia2) | 0.0°11.0′12.0″ S | 78.0°22.0′59.9″ W | 2339 | |
| 40 | Pelargonium hortorum (pink) | 0.0°11.0′14.8″ S | 78.0°22.0′55.1″ W | 2339 | |
| 41 | Pelargonium hortorum (red1) | 0.0°11.0′19.0″ S | 78.0°23.0′46.0″ W | 2360 | |
| 42 | Pelargonium hortorum (red2) | 0.0°10.0′58.7″ S | 78.0°22.0′59.5″ W | 2339 | |
| 43 | Pelargonium hortorum (red-white) | 0.0°11.0′19.0″ S | 78.0°23.0′46.0″ W | 2342 | |
| 44 | Lamiaceae | Salvia microphylla (blue) | 0.0°11.0′19.0″ S | 78.0°23.0′46.0″ W | 2360 |
| 45 | Malvaceae | Hibiscus rosa-sinensis (orange1) | 0.0°12.0′28.5″ N | 78.0°29.0′14.8″ W | 2738 |
| 46 | Hibiscus rosa-sinensis (orange2) | 0.0°12.0′28.5″ N | 78.0°29.0′14.8″ W | 2738 | |
| 47 | Hibiscus rosa-sinensis (pink 1) | 0.0°12.0′28.5″ N | 78.0°29.0′14.8″ W | 2738 | |
| 48 | Hibiscus rosa-sinensis (pink 2) | 0.0°19.0′0.0″ S | 78.0°22.0′59.9″ W | 2644 | |
| 49 | Hibiscus rosa-sinensis (red 1) | 0.0°12.0′28.5″ N | 78.0°29.0′14.8″ W | 2738 | |
| 50 | Hibiscus rosa-sinensis (red 2) | 0.0°53.0′0.9″ N | 79.0°47.0′59.9″ W | 25 | |
| 51 | Hibiscus rosa-sinensis (yellow) | 0.0°12.0′28.5″ N | 78.0°29.0′14.8″ W | 2738 | |
| 52 | Malvaviscus arboreus (red) | 1.0°23.0′35.0″ S | 78.0°26.0′47.0″ W | 1850 | |
| 53 | Nyctaginaceae | Mirabilis jalapa (fuchsia) | 0.0°6.7′31.0″ S | 78.0°27.0′39.6″ W | 2681 |
| 54 | Onagraceae | Fuchsia magellanica (pink) | 0.0°11.0′19.0″ S | 78.0°23.0′46.0″ W | 2360 |
| 55 | Plantaginaceae | Antirrhinum majus (red) | 0.0°9.0′0.0″ S | 78.0°25.0′60.0″ W | 2600 |
| 56 | Antirrhinum majus (yellow) | 0.0°11.0′1.4″ S | 78.0°22.0′59.9″ W | 2339 | |
| 57 | Rosaceae | Rosa banksiae (white) | 0.0°22.6′58.5″ S | 78.0°33.2′15.0″ W | 2945 |
| 58 | Rosa canina (pink) | 1.0°23.0′43.0″ S | 78.0°26.0′18.0″ W | 1600 | |
| 59 | Rosa damascene (pink) | 0.0°15.0′0.4″ S | 78.0°28.0′59.9″ W | 2929 | |
| 60 | Rosa x hybrid big pink | 13.0°13.0′0.0″ S | 78.0°24.0′0.0″ W | 2324 | |
| 61 | Rosa x hybrid big red | 13.0°13.0′0.0″ S | 78.0°24.0′0.0″ W | 2325 | |
| 62 | Rosa x hybrid big white | 13.0°13.0′0.0″ S | 78.0°24.0′0.0″ W | 2325 | |
| 63 | Rosa x hybrid big yellow | 13.0°13.0′0.0″ S | 78.0°24.0′0.0″ W | 2325 | |
| 64 | Rosa x hybrid medium (orange-yellow) | 0.0°9.0′0.0″ S | 78.0°25.0′60.0″ W | 2600 | |
| 65 | Rosa x hybrid medium orange | 0.0°9.0′0.0″ S | 78.0°25.0′60.0″ W | 2600 | |
| 66 | Rosa x hybrid medium pink | 0.0°9.0′0.0″ S | 78.0°25.0′60.0″ W | 2600 | |
| 67 | Rosa x hybrid medium purple | 0.0°9.0′0.0″ S | 78.0°25.0′60.0″ W | 2600 | |
| 68 | Rosa x hybrid medium red | 0.0°9.0′0.0″ S | 78.0°25.0′60.0″ W | 2600 | |
| 69 | Rosa x hybrid medium white | 0.0°9.0′0.0″ S | 78.0°25.0′60.0″ W | 2600 | |
| 70 | Rosa x hybrid medium yellow | 0.0°9.0′0.0″ S | 78.0°25.0′60.0″ W | 2600 | |
| 71 | Rosa x hybrid mini red | 0.0°26.0′0.1″ S | 78.0°32.0′0.6″ W | 2750 | |
| 72 | Rosa x hybrid mini orange | 0.0°26.0′0.1″ S | 78.0°32.0′0.6″ W | 2750 | |
| 73 | Rosa x hybrid mini red | 0.0°26.0′0.1″ S | 78.0°32.0′0.6″ W | 2750 | |
| 74 | Rosa x hybrid mini yellow | 0.0°26.0′0.1″ S | 78.0°32.0′0.6″ W | 2750 | |
| 75 | Rosa x hybrid roseta medium orange-yellow | 0.0°9.0′0.0″ S | 78.0°25.0′60.0″ W | 2600 | |
| 76 | Rosa x hybrid roseta medium orange | 0.0°9.0′0.0″ S | 78.0°25.0′60.0″ W | 2600 | |
| 77 | Rosa x hybrid roseta medium purple | 0.0°9.0′0.0″ S | 78.0°25.0′60.0″ W | 2600 | |
| 78 | Rosa x hybrid roseta medium pink | 0.0°9.0′0.0″ S | 78.0°25.0′60.0″ W | 2600 | |
| 79 | Rosa x hybrid roseta medium red | 0.0°9.0′0.0″ S | 78.0°25.0′60.0″ W | 2600 | |
| 80 | Rosa x hybrid roseta mini pink | 0.0°9.0′0.0″ S | 78.0°25.0′60.0″ W | 2600 | |
| 81 | Rosa x hybrid roseta mini white | 0.0°9.0′0.0″ S | 78.0°25.0′60.0″ W | 2600 | |
| 82 | Rosa x hybrid roseta big purple | 0.0°10.0′58.7″ S | 78.0°22.0′59.5″ W | 2339 | |
| 83 | Rosa x hybrid roseta big red | 0.0°11.0′19.0″ S | 78.0°23.0′46.0″ W | 2360 | |
| 84 | Rosa x hybrid rosetabig pink-white | 0.0°11.0′19.0″ S | 78.0°23.0′46.0″ W | 2360 | |
| 85 | Rosa x hybrid roseta big yellow | 0.0°11.0′19.0″ S | 78.0°23.0′46.0″ W | 2360 | |
| 86 | Rutaceae | Citrus x aurantifolia (white) | 0.0°11.0′19.0″ S | 78.0°23.0′46.0″ W | 2360 |
| 87 | Ruda chalepensis (yellow) | 0.0°11.0′19.0″ S | 78.0°23.0′46.0″ W | 2360 | |
| 88 | Verbenaceae | Aloysia citriodora (fuchsia) | 0.0°6.0′28.3″ S | 78.0°26.0′51.9″ W | 2654 |
| 89 | Lantana camara multicolor | 0.0°11.0′19.0″ S | 78.0°23.0′46.0″ W | 2360 | |
| 90 | Lantana viburnoides (red) | 0.0°12.0′3.9″ S | 78.0°23.0′45.9″ W | 2359 | |
| 91 | Lantana viburnoides (red-orange) | 0.0°12.0′19.8″ S | 78.0°22.0′59.9″ W | 2359 | |
| 92 | Lantana viburnoides (yellow) | 0.0°12.0′3.9″ S | 78.0°23.0′45.9″ W | 2359 | |
| 93 | Lantana viburnoides (white) | 0.0°12.0′3.9″ S | 78.0°23.0′45.9″ W | 2359 | |
| N° | Flower Extracts | Extract Concentration (mg/mL) |
|---|---|---|
| 3 | C. x hybrid (orange) | 521.2 |
| 6 | H. annuus (yellow) | 102.2 |
| 7 | T. patula (orange) | 229.3 |
| 12 | C. indica (red) | 395.7 |
| 45 | H. rosa-sinensis (orange1) | 255.6 |
| 51 | H. rosa-sinensis (yellow) | 424.6 |
| 89 | L. camara | 128.2 |
| 19 | P. hortorum (orange2) | 136.5 |
| 49 | H. rosa-sinensis (red1) | 134.0 |
| 70 | Rosa x hybrid medium red | 218.5 |
| N° | Family | Scientific Name | Total Carotenoids (mg β-Carotene/100 g DW) | Total Phenols (mg GAE/g DW) | % Inhibition ABTS•+ | Antioxidant Activity (TEmmol/100 g DW) | ||||||||
|---|---|---|---|---|---|---|---|---|---|---|---|---|---|---|
| 1 | Apiaceae | Anethum graveolens (yellow) | 467.62 | ± | 1.11 | 254.66 | ± | 17.10 | 34.67 | ± | 0.28 | 277.58 | ± | 2.53 |
| 2 | Asteraceae | Chrysanthemum x hybrid (pink) | 57.65 | ± | 8.24 | 245.36 | ± | 2.24 | 86.91 | ± | 0.35 | 676.32 | ± | 2.99 |
| 3 | Chrysanthemum x hybrid (orange) | 1103.46 | ± | 5.13 | 155.25 | ± | 0.73 | 38.73 | ± | 0.80 | 209.54 | ± | 41.89 | |
| 4 | Chrysanthemum x hybrid (yellow) | 514.56 | ± | 2.15 | 100.89 | ± | 3.06 | 55.67 | ± | 1.23 | 408.15 | ± | 10.58 | |
| 5 | Chrysanthemum x hybrid (yellow-double) | 426.39 | ± | 7.41 | 199.09 | ± | 4.02 | 59.32 | ± | 1.07 | 504.99 | ± | 9.77 | |
| 6 | Helianthus annuus (yellow) | 5154.64 | ± | 0.51 | 77.42 | ± | 0.97 | 68.47 | ± | 0.88 | 463.45 | ± | 6.98 | |
| 7 | Tagetes patula (orange) | 2057.79 | ± | 3.66 | 194.84 | ± | 15.99 | 83.77 | ± | 0. 73 | 623.65 | ± | 6.55 | |
| 8 | Tagetes patula (yellow) | 500.62 | ± | 3.05 | 303.61 | ± | 2.39 | 83.89 | ± | 0.39 | 624.71 | ± | 3.51 | |
| 9 | Begoniaceae | Begonia doblet (pink) | 194.69 | ± | 5.33 | 275.17 | ± | 1.19 | 41.35 | ± | 3.63 | 342.91 | ± | 33.21 |
| 10 | Brasicaceae | Raphanus raphanistrum (pink) | 270.83 | ± | 22.53 | 278.38 | ± | 13.64 | 80.42 | ± | 0.74 | 524.83 | ± | 5.34 |
| 11 | Cannaceae | Canna indica (red-double) | 78.86 | ± | 11.03 | 261.56 | ± | 10.66 | 77.01 | ± | 2.61 | 661.55 | ± | 24.15 |
| 12 | Canna indica (red) | 1223.51 | ± | 5.33 | 250.09 | ± | 16.09 | 53.80 | ± | 6.65 | 451.46 | ± | 63.01 | |
| 13 | Canna indica (yellow-orange) | 1021.44 | ± | 8.54 | 115.21 | ± | 5.01 | 58.89 | ± | 2.64 | 491.29 | ± | 23.58 | |
| 14 | Caryophyllaceae | Dianthus chinensis (pink) | 49.05 | ± | 3.24 | 248.57 | ± | 11.71 | 70.56 | ± | 1.12 | 604.40 | ± | 10.15 |
| 15 | Dianthus chinensis (red) | 75.90 | ± | 5.85 | 179.63 | ± | 4.53 | 81.62 | ± | 0.67 | 523.76 | ± | 3.41 | |
| 16 | Pelargonium hortorum (fuchsia1) | 124.56 | ± | 2.32 | 274.22 | ± | 11.13 | 83.15 | ± | 1.32 | 544.64 | ± | 9.60 | |
| 17 | Pelargonium hortorum (fuchsia2) | 94.16 | ± | 1.05 | 286.11 | ± | 4.20 | 85.67 | ± | 0.71 | 530.57 | ± | 5.06 | |
| 18 | Pelargonium hortorum (orange1) | 144.54 | ± | 1.37 | 331.34 | ± | 8.52 | 79.24 | ± | 0.49 | 516.28 | ± | 3.52 | |
| 19 | Pelargonium hortorum (orange2) | 156.30 | ± | 3.58 | 525.39 | ± | 3.94 | 85.99 | ± | 0.19 | 532.90 | ± | 1.37 | |
| 20 | Pelargonium hortorum (pink1) | 95.01 | ± | 3.06 | 218.09 | ± | 4.78 | 86.41 | ± | 0.48 | 504.54 | ± | 3.22 | |
| 21 | Pelargonium hortorum (pink2) | 202.73 | ± | 2.54 | 281.33 | ± | 9.29 | 83.22 | ± | 1.17 | 545.13 | ± | 8.48 | |
| 22 | Pelargonium hortorum (pink3) | 170.33 | ± | 0.71 | 193.74 | ± | 14.01 | 82.42 | ± | 0.53 | 539.40 | ± | 3.83 | |
| 23 | Pelargonium hortorum (pink4) | 81.18 | ± | 1.38 | 302.90 | ± | 2.11 | 86.14 | ± | 0.41 | 427.52 | ± | 9.38 | |
| 24 | Pelargonium hortorum (pink-fuchsia) | 67.84 | ± | 0.82 | 226.40 | ± | 1.17 | 83.22 | ± | 0.73 | 545.13 | ± | 5.32 | |
| 25 | Pelargonium hortorum (pink-white1) | 113.10 | ± | 1.21 | 279.99 | ± | 11.98 | 84.95 | ± | 0.59 | 494.80 | ± | 3.95 | |
| 26 | Pelargonium hortorum (pink-white2) | 80.71 | ± | 5.43 | 334.18 | ± | 11.94 | 83.75 | ± | 0.59 | 549.01 | ± | 4.27 | |
| 27 | Pelargonium hortorum (red1) | 88.19 | ± | 9.06 | 110.74 | ± | 0.33 | 84.38 | ± | 0.16 | 442.75 | ± | 94.64 | |
| 28 | Pelargonium hortorum (red2) | 135.12 | ± | 0.64 | 314.14 | ± | 7.65 | 80.74 | ± | 0.40 | 527.16 | ± | 2.89 | |
| 29 | Pelargonium hortorum (white1) | 32.38 | ± | 4.38 | 151.86 | ± | 13.25 | 84.34 | ± | 0.79 | 479.21 | ± | 93.78 | |
| 30 | Pelargonium hortorum (white2) | 91.15 | ± | 0.06 | 134.56 | ± | 4.21 | 85.45 | ± | 0.85 | 529.03 | ± | 6.06 | |
| 31 | Compositae | Calendula officinalis(yellow) | 5745.28 | ± | 58.55 | 290.74 | ± | 5.87 | 88.88 | ± | 2.01 | 771.03 | ± | 23.90 |
| 32 | Chamaemelun nobile (white) | 63.89 | ± | 3.86 | 16.49 | ± | 0.05 | 4.57 | ± | 0.41 | 6.01 | ± | 3.65 | |
| 33 | Dahlia pinnata (fuchsia1) | 78.64 | ± | 0.09 | 280.21 | ± | 10.59 | 61.71 | ± | 0.54 | 523.11 | ± | 5.86 | |
| 34 | Dahlia pinnata (fuchsia2) | 98.48 | ± | 0.91 | 338.60 | ± | 22.50 | 75.48 | ± | 1.21 | 649.61 | ± | 6.61 | |
| 35 | Dahlia pinnata (orange) | 931.92 | ± | 6.98 | 327.77 | ± | 14.01 | 90.86 | ± | 0.48 | 796.35 | ± | 4.39 | |
| 36 | Dahlia pinnata (red) | 282.91 | ± | 2.09 | 337.46 | ± | 8.22 | 83.67 | ± | 0.65 | 718.24 | ± | 6.00 | |
| 37 | Fabaceae | Trifolium repens (white) | 260.37 | ± | 9.40 | 167.76 | ± | 11.06 | 81.43 | ± | 0.95 | 554.16 | ± | 7.25 |
| 38 | Geraniaceae | Pelargonium hortorum (fuchsia1) | 131.47 | ± | 0.39 | 311.74 | ± | 1.92 | 79.88 | ± | 0.75 | 695.77 | ± | 6.90 |
| 39 | Pelargonium hortorum (fuchsia2) | 94.67 | ± | 10.59 | 162.11 | ± | 10.37 | 86.24 | ± | 0.68 | 607.50 | ± | 5.14 | |
| 40 | Pelargonium hortorum (pink) | 76.02 | ± | 0.67 | 155.99 | ± | 17.36 | 90.91 | ± | 0.18 | 785.79 | ± | 3.69 | |
| 41 | Pelargonium hortorum (red1) | 109.83 | ± | 2.02 | 262.59 | ± | 0.40 | 88.71 | ± | 0.42 | 776.60 | ± | 3.88 | |
| 42 | Pelargonium hortorum (red2) | 58.98 | ± | 2.29 | 203.96 | ± | 5.41 | 84.39 | ± | 1.07 | 576.72 | ± | 8.13 | |
| 43 | Pelargonium hortorum (red-white) | 76.63 | ± | 9.23 | 316.99 | ± | 17.67 | 89.69 | ± | 1.46 | 785.63 | ± | 13.40 | |
| 44 | Lamiaceae | Salvia microphylla (blue) | 134.76 | ± | 3.26 | 293.39 | ± | 13.02 | 53.73 | ± | 0.91 | 452.66 | ± | 9.08 |
| 45 | Malvaceae | Hibiscus rosa-sinensis (orange1) | 1034.10 | ± | 37.81 | 348.88 | ± | 10.47 | 88.02 | ± | 2.34 | 755.24 | ± | 20.97 |
| 46 | Hibiscus rosa-sinensis (orange2) | 430.61 | ± | 7.48 | 257.00 | ± | 15.57 | 52.78 | ± | 7.77 | 441.30 | ± | 69.59 | |
| 47 | Hibiscus rosa-sinensis (pink 1) | 116.47 | ± | 0.55 | 253.52 | ± | 19.15 | 53.33 | ± | 9.25 | 449.54 | ± | 84.35 | |
| 48 | Hibiscus rosa-sinensis (pink 2) | 137.86 | ± | 2.64 | 207.38 | ± | 15.31 | 74.85 | ± | 5.49 | 641.90 | ± | 48.50 | |
| 49 | Hibiscus rosa-sinensis (red 1) | 125.36 | ± | 0.77 | 343.84 | ± | 16.84 | 75.80 | ± | 12.67 | 649.25 | ± | 2.05 | |
| 50 | Hibiscus rosa-sinensis (red 2) | 314.62 | ± | 0.76 | 152.00 | ± | 8.54 | 83.69 | ± | 0.29 | 571.38 | ± | 2.19 | |
| 51 | Hibiscus rosa-sinensis (yellow) | 2468.50 | ± | 6.75 | 353.82 | ± | 6.85 | 62.50 | ± | 14.56 | 529.24 | ± | 93.78 | |
| 52 | Malvaviscus arboreus (red) | 88.76 | ± | 5.86 | 178.51 | ± | 15.79 | 78.61 | ± | 0.97 | 672.06 | ± | 9.98 | |
| 53 | Nyctaginaceae | Mirabilis jalapa (fuchsia) | 277.88 | ± | 1.67 | 119.36 | ± | 0.24 | 85.42 | ± | 1.06 | 446.95 | ± | 85.86 |
| 54 | Onagraceae | Fuchsia magellanica (pink) | 89.30 | ± | 1.00 | 174.30 | ± | 13.09 | 52.21 | ± | 2.21 | 441.09 | ± | 21.35 |
| 55 | Plantaginaceae | Antirrhinum majus (red) | 230.88 | ± | 2.37 | 200.53 | ± | 6.76 | 84.09 | ± | 0.59 | 626.48 | ± | 5.37 |
| 56 | Antirrhinum majus (yellow) | 399.89 | ± | 5.92 | 101.32 | ± | 4.69 | 38.60 | ± | 2.42 | 315.22 | ± | 22.46 | |
| 57 | Rosaceae | Rosa banksiae (white) | 150.51 | ± | 1.57 | 199.68 | ± | 11.96 | 87.25 | ± | 5.55 | 753.98 | ± | 46.32 |
| 58 | Rosa canina (pink) | 93.39 | ± | 0.27 | 194.49 | ± | 9.51 | 88.73 | ± | 0.17 | 775.30 | ± | 3.41 | |
| 59 | Rosa damascene (pink) | 132.55 | ± | 5.38 | 107.02 | ± | 1.83 | 85.72 | ± | 0.91 | 746.96 | ± | 7.42 | |
| 47 | Hibiscus rosa-sinensis (pink 1) | 116.47 | ± | 0.55 | 253.52 | ± | 19.15 | 53.33 | ± | 9.25 | 449.54 | ± | 84.35 | |
| 60 | Rosa x hybrid big pink | 79.36 | ± | 1.06 | 86.13 | ± | 0.32 | 86.74 | ± | 0.71 | 526.08 | ± | 5.20 | |
| 61 | Rosa x hybrid big red | 69.75 | ± | 3.00 | 150.34 | ± | 0.24 | 86.42 | ± | 0.28 | 523.79 | ± | 2.05 | |
| 62 | Rosa x hybrid big white | 74.23 | ± | 1.42 | 203.63 | ± | 1.75 | 86.99 | ± | 0.50 | 527.97 | ± | 3.65 | |
| 63 | Rosa x hybrid big yellow | 600.70 | ± | 1.78 | 69.23 | ± | 0.24 | 86.32 | ± | 0.57 | 523.00 | ± | 4.18 | |
| 64 | Rosa x hybrid medium (orange-yellow) | 289.21 | ± | 5.38 | 110.67 | ± | 6.67 | 84.03 | ± | 0.44 | 488.71 | ± | 2.93 | |
| 65 | Rosa x hybrid medium orange | 143.24 | ± | 0.97 | 324.84 | ± | 13.96 | 85.17 | ± | 0.84 | 496.33 | ± | 5.63 | |
| 66 | Rosa x hybrid medium pink | 66.94 | ± | 1.52 | 361.29 | ± | 6.90 | 85.68 | ± | 1.04 | 603.24 | ± | 7.93 | |
| 67 | Rosa x hybrid medium purple | 81.31 | ± | 0.55 | 350.94 | ± | 6.05 | 82.94 | ± | 0.67 | 481.43 | ± | 4.48 | |
| 68 | Rosa x hybrid medium red | 52.16 | ± | 1.64 | 160.88 | ± | 6.14 | 85.24 | ± | 0.32 | 599.93 | ± | 2.43 | |
| 69 | Rosa x hybrid medium white | 89.70 | ± | 2.89 | 359.12 | ± | 9.45 | 83.94 | ± | 0.26 | 488.12 | ± | 1.70 | |
| 70 | Rosa x hybrid medium yellow | 206.10 | ± | 0.39 | 363.90 | ± | 8.40 | 83.70 | ± | 0.53 | 486.51 | ± | 3.52 | |
| 71 | Rosa x hybrid mini red | 116.33 | ± | 0.28 | 586.37 | ± | 26.34 | 83.89 | ± | 0.73 | 487.78 | ± | 4.85 | |
| 72 | Rosa x hybrid mini orange | 660.13 | ± | 0.69 | 256.64 | ± | 0.98 | 86.24 | ± | 0.45 | 534.64 | ± | 3.20 | |
| 73 | Rosa x hybrid mini red | 55.31 | ± | 6.84 | 307.49 | ± | 0.99 | 85.69 | ± | 0.85 | 425.19 | ± | 94.67 | |
| 74 | Rosa x hybrid mini yellow | 512.81 | ± | 8.57 | 195.20 | ± | 3.50 | 85.33 | ± | 0.65 | 422.87 | ± | 8.13 | |
| 75 | Rosa x hybrid roseta medium orange-yellow | 209.09 | ± | 11.52 | 150.09 | ± | 2.73 | 82.56 | ± | 0.60 | 478.90 | ± | 3.99 | |
| 76 | Rosa x hybrid roseta medium orange | 107.67 | ± | 5.33 | 265.97 | ± | 10.40 | 84.55 | ± | 0.93 | 492.18 | ± | 6.22 | |
| 77 | Rosa x hybrid roseta medium purple | 131.93 | ± | 0.91 | 246.13 | ± | 6.19 | 84.39 | ± | 0.65 | 491.08 | ± | 4.36 | |
| 78 | Rosa x hybrid roseta medium pink | 61.33 | ± | 1.27 | 164.46 | ± | 5.34 | 85.23 | ± | 0.27 | 599.82 | ± | 2.08 | |
| 79 | Rosa x hybrid roseta medium red | 64.76 | ± | 4.69 | 275.10 | ± | 14.15 | 86.18 | ± | 0.74 | 503.01 | ± | 4.91 | |
| 80 | Rosa x hybrid roseta mini pink | 107.06 | ± | 4.35 | 323.12 | ± | 7.17 | 84.90 | ± | 0.79 | 494.47 | ± | 5.25 | |
| 81 | Rosa x hybrid roseta mini white | 87.51 | ± | 2.86 | 225.17 | ± | 6.76 | 84.63 | ± | 0.40 | 492.69 | ± | 2.65 | |
| 82 | Rosa x hybrid roseta big purple | 56.49 | ± | 0.55 | 290.73 | ± | 1.47 | 82.74 | ± | 0.65 | 577.14 | ± | 5.17 | |
| 83 | Rosa x hybrid roseta big red | 122.44 | ± | 0.1 | 259.55 | ± | 11.65 | 88.02 | ± | 0.85 | 761.98 | ± | 11.56 | |
| 84 | Rosa x hybrid rosetabig pink-white | 103.33 | ± | 0.22 | 223.22 | ± | 13.80 | 87.43 | ± | 1.21 | 761.88 | ± | 8.52 | |
| 85 | Rosa x hybrid roseta big yellow | 361.80 | ± | 15.57 | 96.51 | ± | 0.40 | 34.34 | ± | 0.71 | 276.79 | ± | 6.31 | |
| 86 | Rutaceae | Citrus x aurantifolia (white) | 96.61 | ± | 3.55 | 65.40 | ± | 6.39 | 100.00 | ± | 0.00 | 874.81 | ± | 6.72 |
| 87 | Ruda chalepensis (yellow) | 923.26 | ± | 13.68 | 217.59 | ± | 6.60 | 90.26 | ± | 0.79 | 784.56 | ± | 8.54 | |
| 88 | Verbenaceae | Aloysia citriodora (fuchsia) | 173.28 | ± | 5.08 | 222.85 | ± | 8.11 | 84.18 | ± | 0.26 | 552.12 | ± | 1.91 |
| 89 | Lantana camara multicolor | 2947.72 | ± | 34.92 | 182.40 | ± | 3.27 | 40.70 | ± | 0.73 | 332.60 | ± | 6.33 | |
| 90 | Lantana viburnoides (red) | 197.57 | ± | 0.69 | 259.28 | ± | 2.57 | 80.36 | ± | 1.00 | 545.42 | ± | 7.86 | |
| 91 | Lantana viburnoides (red-orange) | 658.02 | ± | 3.42 | 224.94 | ± | 12.33 | 13.14 | ± | 5.33 | 82.93 | ± | 3.51 | |
| 92 | Lantana viburnoides (yellow) | 211.53 | ± | 0.82 | 65.98 | ± | 2.04 | 76.08 | ± | 1.04 | 511.61 | ± | 8.23 | |
| 93 | Lantana viburnoides (white) | 42.81 | ± | 2.49 | 101.39 | ± | 1.67 | 78.51 | ± | 0.57 | 459.60 | ± | 8.95 | |
| High Concentrations of Total Carotenoids | High Concentrations of Total Phenolics | ||||||||||||||||||||||||||
|---|---|---|---|---|---|---|---|---|---|---|---|---|---|---|---|---|---|---|---|---|---|---|---|---|---|---|---|
| (3) C. x hybrid (Orange) | (6) H. annuus (Yellow) | (7) T. patula (Orange) | (12) C. indica (Red) | (45) H. rosa-sinensis (Orange1) | (51) H. rosa-sinensis (Yellow) | (19) P. hortorum (Orange2) | (49) H. rosa-sinensis (Red1) | (70) Rosa x hybrid Medium Red | |||||||||||||||||||
| Organic acid (mg/g DW) | |||||||||||||||||||||||||||
| Tartaric acid | 23.0 | ± | 1.6 f | 21.0 | ± | 0.5 f | 32.4 | ± | 0.4 d | 113.8 | ± | 1.6 a | 18.2 | ± | 0.4 g | 11.2 | ± | 1.2 h | 48.8 | ± | 1.2 b | 29.6 | ± | 0.0 e | 37.3 | ± | 0.0 c |
| Malic acid | 13.0 | ± | 1.3 d | 24.1 | ± | 0.6 c | 7.4 | ± | 0.5 e | 81.7 | ± | 3.3 b | 6.2 | ± | 0.2 e | 9.2 | ± | 0.1 e | 119.7 | ± | 1.2 a | 12.4 | ± | 0.5 d | 26.3 | ± | 3.4 c |
| Citric acid | 140.5 | ± | 0.4 e | 8.9 | ± | 0.4 g | 11.0 | ± | 0.1 fg | 11.5 | ± | 0.3 fg | 910.7 | ± | 6.8 b | 931.9 | ± | 4.1 c | 301.5 | ± | 7.6 d | 991.4 | ± | 2.1 a | 18.2 | ± | 1.7 f |
| Total | 176.5 | ± | 0.8 f | 54.0 | ± | 1.5 h | 50.9 | ± | 0.2 h | 206.9 | ± | 5.3 e | 1127.1 | ± | 6.6 b | 952.3 | ± | 2.1 c | 470.0 | ± | 10.0 d | 1233.4 | ± | 0.0 a | 18.2 | ± | 1.7 g |
| Phenolics (mg/100 g DW) | |||||||||||||||||||||||||||
| Gallic acid | 2.8 | ± | 0.0 c | 0.5 | ± | 0.0 d | 0.1 | ± | 0.0 e | 0.3 | ± | 0.0 e | 0.2 | ± | 0.0 e | 17.2 | ± | 1.4 a | 0.6 | + | 0.0 d | 5.6 | + | 0.1 b | |||
| Vanillic acid | 0.6 | ± | 0.0 a | 0.2 | ± | 0.0 b | 0.5 | ± | 0.0 a | ||||||||||||||||||
| p-Cumaric acid | 2.8 | ± | 0.0 b | 38.9 | ± | 0.7 a | |||||||||||||||||||||
| m-Cumaric acid | 27.4 | ± | 0.1 b | 52.0 | ± | 0.8 a | 18.0 | + | 0.6 c | ||||||||||||||||||
| Siringic acid | 3.9 | ± | 0.4 | ||||||||||||||||||||||||
| Chlorogenic acid | 0.8 | ± | 0.1 b | 1.2 | ± | 0.1 a | |||||||||||||||||||||
| Caffeic acid | 2.2 | ± | 0.0 b | 3.6 | ± | 0.5 a | |||||||||||||||||||||
| Naringin | 8.7 | ± | 1.7 d | 46.1 | ± | 1.5 b | 120.1 | ± | 4.2 a | 24.9 | + | 1.2 c | |||||||||||||||
| Ferulic acid | 13.0 | ± | 0.3 a | 2.5 | ± | 0.1 b | |||||||||||||||||||||
| 4-Hidroxy benzoic acid | 476.6 | ± | 4.7 b | 0.3 | ± | 0.0 d | 936.2 | ± | 32.8 a | 260.7 | + | 0.4 c | |||||||||||||||
| Rutin | 520.1 | ± | 19.9 b | 113.6 | ± | 20.8 e | 465.9 | ± | 5.7 c | 854.3 | ± | 22.8 a | 240.5 | + | 8.8 d | ||||||||||||
| Kampherol | 45.7 | ± | 1.9 | 971.9 | ± | 8.9 a | 83.7 | ± | 6.5 e | 801.6 | ± | 77.2 b | 607.2 | ± | 34.1 c | 639.7 | + | 30.6 c | 163.2 | + | 7.8 d | ||||||
| Quercetin glucoside | 958.8 | ± | 9.5 a | 82.8 | ± | 0.5 d | 936.2 | ± | 79.2 a | 854.4 | ± | 86.8 b | 232.6 | + | 12.2 c | 843.8 | + | 8.5 b | |||||||||
| Quercetin | 919.3 | ± | 43.3 a | 322.3 | ± | 7.5 d | 459.5 | ± | 21.9 c | 170.6 | ± | 1.6 e | 307.2 | + | 15.8 d | 614.0 | + | 25.7 b | |||||||||
| Total | 1958.3 | ± | 5.8 c | 174.9 | ± | 2.2 h | 2827.4 | ± | 44.8 a | 532.2 | ± | 18.3 g | 2683.7 | ± | 17.7 b | 1757.7 | ± | 9.2 d | 992.4 | ± | 33.5 f | 1706.2 | ± | 68.9 de | 1644.7 | ± | 41.3 e |
| Carotenoids (mg/100 g DW) | |||||||||||||||||||||||||||
| α-carotene | 2.4 | ± | 0.0 f | 604.0 | ± | 2.1 b | 989.5 | ± | 1.5 a | 283.6 | ± | 1.7 c | 48.0 | + | 0.1 d | 34.3 | + | 0.3 e | |||||||||
| β-carotene | 7.2 | ± | 0.0 e | 2.4 | ± | 0.0 f | 601.2 | ± | 1.9 a | 372.6 | ± | 1.1 b | 41.6 | + | 0.1 c | 13.2 | + | 0.1 d | 2.5 | + | 0.0 f | ||||||
| β-cryptoxanthin | 22.2 | ± | 0.1 a | 34.2 | 12.1 | + | 0.1 b | ||||||||||||||||||||
| Violaxanthin | 59.5 | ± | 0.2 a | 39.6 | ± | 0.1 b | 23.16 | ± | 0.1 c | ||||||||||||||||||
| Zeaxanthin | 25.7 | ± | 0.1 b | 149.5 | ± | 0.0 a | 4.3 | ± | 0.3 e | 12.0 | + | 0.0 d | 8.9 | + | 0.1 c | ||||||||||||
| Lutein | 2.8 | ± | 0.0 f | 300.9 | ± | 1.1 a | 219.3 | ± | 0.1 b | 19.5 | ± | 0.4 c | 3.7 | + | 0.0 e | 5.2 | + | 0.0 d | |||||||||
| Zeinoxanthin | 3.1 | + | 0.0 a | 1.9 | + | 0.0 b | |||||||||||||||||||||
| Total | 34.6 | ± | 0.2 f | 1187.7 | ± | 4.2 b | 703.1 | ± | 3.7 c | 2043.3 | ± | 3.6 a | 108.3 | ± | 0.2 d | 75.6 | ± | 0.7 e | lnd | 2.5 | ± | 0.0 g | lnd | ||||
| N° | Zone of Inhibition (mm) | ||||||||||||||||||
|---|---|---|---|---|---|---|---|---|---|---|---|---|---|---|---|---|---|---|---|
| Bacterial Strain | Fungal Strain | ||||||||||||||||||
| Flower Extracts | E. coli ATCC 8739 | S. aureus ATCC 6538P | P. aeruginosa ATCC 9027 | S. mutans ATCC 25175 | C. albicans ATCC 1031 | C. tropicalis ATCC 13803 | |||||||||||||
| 3 | C. x hybrid (orange) | - | 12.5 | ± | 0.1 | 11.0 | ± | 0.0 | - | 14.0 | ± | 0.0 | - | ||||||
| 6 | H. annuus (yellow) | - | 9.5 | ± | 0.1 | - | 16.0 | ± | 0.0 | - | - | ||||||||
| 7 | T. patula (orange) | 6.0 | ± | 0.1 | 15.5 | ± | 0.0 | 7.0 | ± | 0.1 | 20.0 | ± | 0.0 | - | - | ||||
| 12 | C. indica (red) | - | - | - | - | - | - | ||||||||||||
| 45 | H. rosa-sinensis (orange1) | 7.0 | ± | 0.1 | 10.5 | ± | 0.0 | 12.3 | ± | 0.1 | 10.0 | ± | 0.0 | - | - | ||||
| 51 | H. rosa-sinensis (yellow) | - | 10.5 | ± | 0.1 | - | - | - | - | ||||||||||
| 89 | L. camara | - | 10.0 | ± | 0.0 | 15.5 | ± | 0.0 | - | - | - | ||||||||
| 19 | P. hortorum (orange2) | 11.0 | ± | 0.2 | 18.0 | ± | 0.0 | 15.0 | ± | 0.0 | 21.0 | ± | 0.0 | 8.0 | ± | 0.0 | 10.0 | + | 0.1 |
| 49 | H. rosa-sinensis (red1) | - | - | - | 15.0 | ± | 0.0 | - | - | ||||||||||
| 70 | Rosa x hybrid medium red | 12.0 | ± | 0.0 | 17.5 | ± | 0.0 | 13.0 | ± | 0.0 | - | - | - | ||||||
| Control * | 22.0 | ± | 0.2 | 24.0 | ± | 1.7 | 23.6 | ± | 1.4 | 29.5 | ± | 3.7 | 18.0 | ± | 0.0 | 14.0 | + | 0.0 | |
Disclaimer/Publisher’s Note: The statements, opinions and data contained in all publications are solely those of the individual author(s) and contributor(s) and not of MDPI and/or the editor(s). MDPI and/or the editor(s) disclaim responsibility for any injury to people or property resulting from any ideas, methods, instructions or products referred to in the content. |
© 2024 by the authors. Licensee MDPI, Basel, Switzerland. This article is an open access article distributed under the terms and conditions of the Creative Commons Attribution (CC BY) license (https://creativecommons.org/licenses/by/4.0/).
Share and Cite
Coyago-Cruz, E.; Alarcón, A.; Guachamin, A.; Méndez, G.; Osorio, E.; Heredia-Moya, J.; Zuñiga-Miranda, J.; Beltrán-Sinchiguano, E.; Vera, E. Functional, Antioxidant, Antibacterial, and Antifungal Activity of Edible Flowers. Antioxidants 2024, 13, 1297. https://doi.org/10.3390/antiox13111297
Coyago-Cruz E, Alarcón A, Guachamin A, Méndez G, Osorio E, Heredia-Moya J, Zuñiga-Miranda J, Beltrán-Sinchiguano E, Vera E. Functional, Antioxidant, Antibacterial, and Antifungal Activity of Edible Flowers. Antioxidants. 2024; 13(11):1297. https://doi.org/10.3390/antiox13111297
Chicago/Turabian StyleCoyago-Cruz, Elena, Alejandro Alarcón, Aida Guachamin, Gabriela Méndez, Edison Osorio, Jorge Heredia-Moya, Johana Zuñiga-Miranda, Elena Beltrán-Sinchiguano, and Edwin Vera. 2024. "Functional, Antioxidant, Antibacterial, and Antifungal Activity of Edible Flowers" Antioxidants 13, no. 11: 1297. https://doi.org/10.3390/antiox13111297
APA StyleCoyago-Cruz, E., Alarcón, A., Guachamin, A., Méndez, G., Osorio, E., Heredia-Moya, J., Zuñiga-Miranda, J., Beltrán-Sinchiguano, E., & Vera, E. (2024). Functional, Antioxidant, Antibacterial, and Antifungal Activity of Edible Flowers. Antioxidants, 13(11), 1297. https://doi.org/10.3390/antiox13111297










